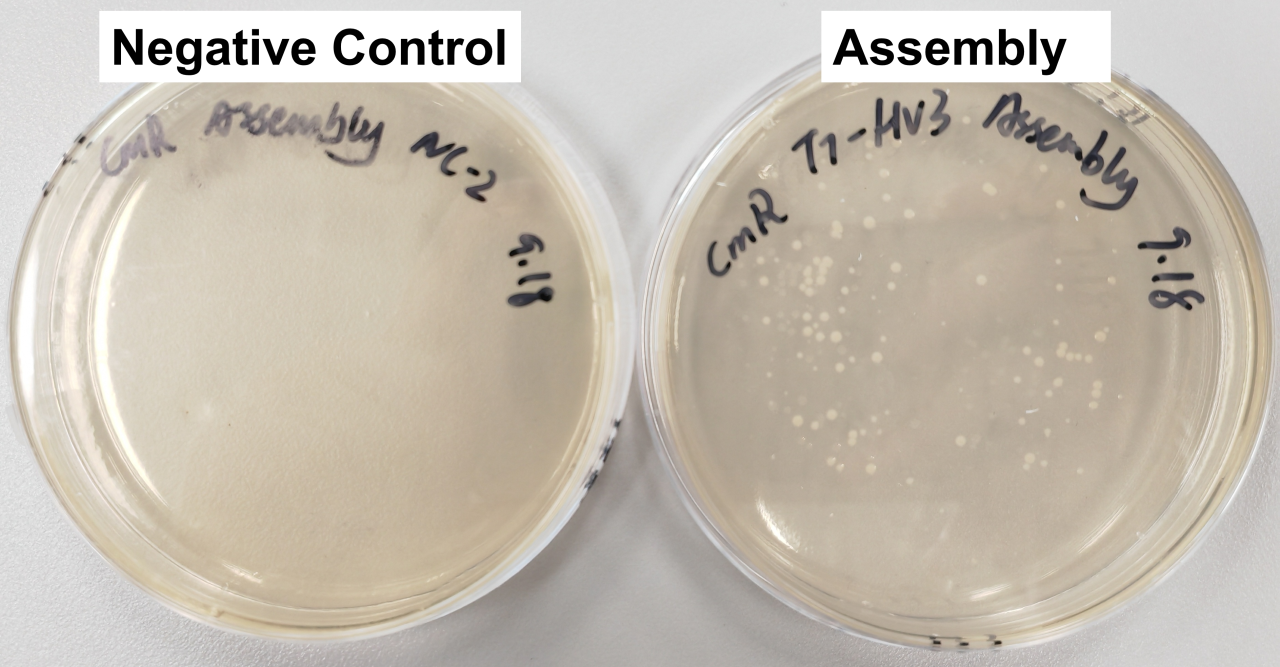
微信图片_20251217081832

iGEM全球银奖 | 365天,从实验室到渔场的生命科学实践BBSG
2025-11-21
十六名心怀热忱的中学生,因对生命科学共同的好奇与向往,在2024年11月组成了博萃德首支iGEM团队。他们像一个精密运作的“科研团队”,各展所长、紧密配合:有的在实验室中探秘分子与细胞的微观世界,有的深入社会开展调研,为项目注入人文温度;还有一部分团队成员负责制作视频、搭建网站,将科学成果生动呈现给公众。
在项目导师、跨学科教师顾问和行业专业人士的支持下,这支多元互补的团队实现了从项目策划、科学调研、实验验证,到成果呈现与推广的完整闭环。最终,博萃德iGEM项目在国际舞台大放异彩,凭借出色的项目成果斩获2025年国际基因工程机器大赛(iGEM)银奖。

用“水蛭分子”拯救鱼的“心脏”
人类心血管疾病是全球首要死亡原因,但你知道吗?鱼类也会患上“心脏病”。在养殖场中,很多鱼因血栓死亡,却常常难以被发现。
BBSG iGEM团队将研究目光投向一种奇妙的天然分子——水蛭素。这种物质早在一个多世纪前就被用于治疗人类心血管疾病,具有强大的抗凝血作用。团队提出了一个大胆的设想:如果水蛭素能够保护人类的心脏,它是否也能“治愈”鱼的心脏?


iGEM团队开展重组复合蛋白实验
为了验证这一想法,学生们查阅了大量文献和基因数据库,锁定了12种不同水蛭物种的水蛭素基因,并利用生物合成技术对其进行重建。他们引入绿色荧光蛋白(GFP)基因作为标记,系统比较不同水蛭素的抗血栓效果,力求筛选出最优候选,为降低水产养殖中鱼类血栓死亡率提供新的可能。
实验组与对照组菌落生长对比,
说明同源重组成功并获得阳性克隆

菌落PCR筛选结果
这不仅是一次严谨、系统的科学实验,更是一场融合生物学、医学与动物福祉的跨学科探索,诠释了“以自然之道,疗愈自然之疾”的可持续理念。团队希望最终能建立一套适用于养殖环境的给药系统,并开发早期识别鱼类凝血异常的方法,让鱼类活得更健康、更长久。
从课堂到世界
让科学落地,与人文共鸣
科学研究不仅仅是实验室里的数据与试管,更是一场关于人、自然与社会的对话。为了让项目真正“走出实验室、服务现实”,团队开启了一场贯穿全年的人文实践之旅。
从与专家的初步探讨,到在各类活动中不断汲取灵感、收集反馈、完善方案,再到将科研成果分享给公众,他们让科学研究始终与现实世界同频。
人文实践之旅
走进由华大基因集团举办的国际基因组学大会(ICG),了解前沿科学研究,为项目选题提供现实参考

探访香港科技大学(广州)实验室,与其iGEM团队交流经验,学习实验设计与应用思路


向全科医生田芳博士了解心脑血管疾病的临床特征与应对方法

参观广东中医药大学,了解中医药在心脏疾病实际治疗中的应用

探访我国最大的“蚊子工厂”(中山大学蚊子工厂),探索从蚊子提取抗凝剂应用于实验的可行性

实地走访香港商业化养鱼场,了解现代水产养殖的运营模式及实际问题


面对面交流世界级科学家,如未来科学大奖生物奖得主柴继杰教授、赵炳然研究员,加深对科研应用价值的理解


参与广州最大Toastmasters俱乐部会议,学习专业演讲与科普传播,将科学成果带向公众

持续一年的探索,让学生们看到:科学不仅是追求知识的过程,更是理解世界、改善生活的方式。
“这段旅程让我们深刻体会到:科学不止于实验室,更源于人类的精神力量。科学家的热情、坚韧与奉献,激励着我们以更宽广的视野理解科研的意义。”
—— 博萃德iGEM团队
成长的意义
从学习者到引领者
作为iGEM项目的总导师,Gert Grobler 博士感慨道:“在这一年中,学生们不仅拓展了生物学认知,更在实践中锤炼了研究、沟通、编程、艺术设计与项目管理等综合能力。他们学会协作、敢于创新,更懂得如何融合多学科知识,回应真实世界的挑战。很多时候,他们自己并未察觉成长的速度,但改变已悄然发生。我为他们感到骄傲。”


项目接近尾声之时,iGEM团队在校园发起“Gopher Science”项目(英国皇家生物学会认证课程),以课程设计者和知识传递者的身份,为5-6年级学弟学妹讲授生物知识,引导他们动手操作、主动思考。
从学习者到引领者,知识在传递中丰盈,热爱也在探索中延续。
在完成这一年的科研旅程后,博萃德即将携手英国博耐顿,共同组队出战下一届 iGEM赛事!
两校已初步完成线上头脑风暴,期待选定一个令双方学生都为之振奋的科研主题,在此基础上开展后续研究。未来,他们将融合东西方文化视角,将科学置于全球化的背景下,面对真实问题、进行实际验证,让科研成为理解世界、改善生活的实践。
期待这群年轻科学家用好奇心与创造力,再次带来令人惊喜的成果。
